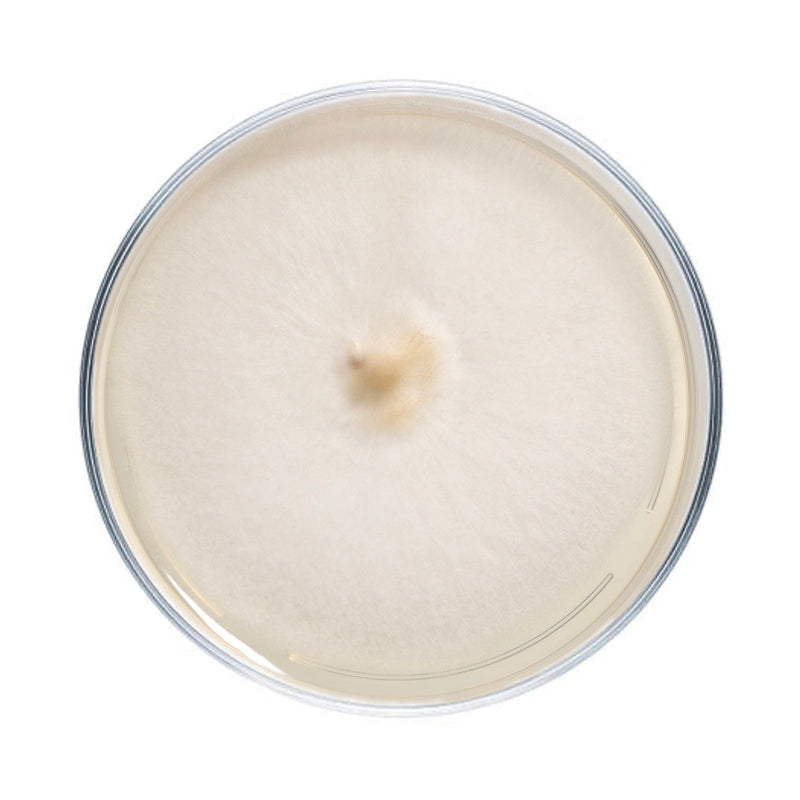
Culture Pioppino Mushroom Agar Plate Culture
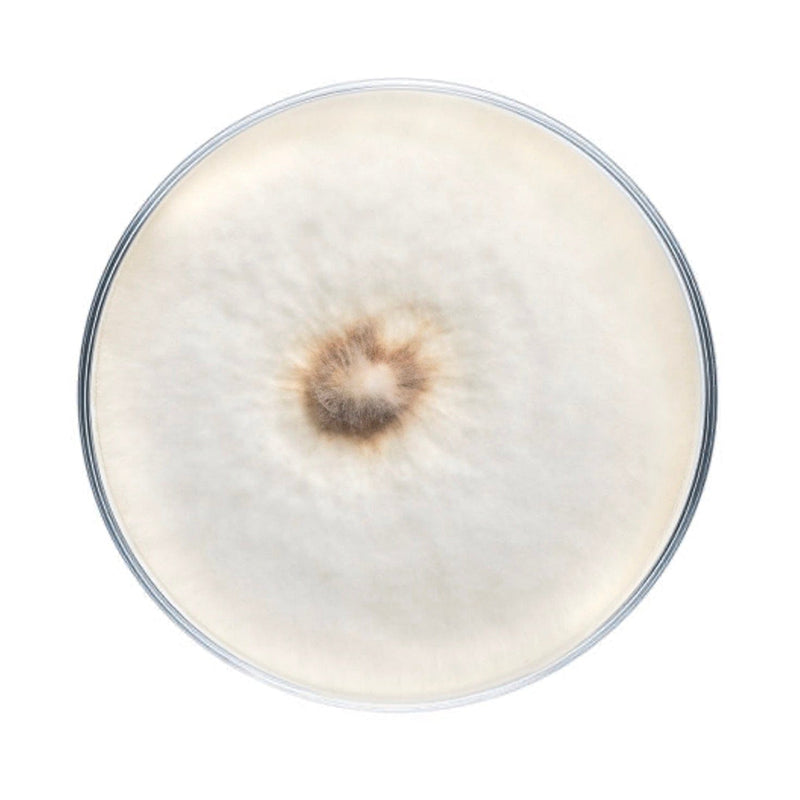
Culture Pioppino Mushroom Plate Culture

Pioppino Mushroom Plate Culture
Plate cultures are ideal for growers looking to make master bags, inoculate grain, make liquid culture, or make more plates.
Our pioppino plates are made to order in our in-house lab using medical-grade petri dishes. If properly stored upon arrival, they have a shelf life of approximately 6 months. Pioppino plates should be stored in the refrigerator to maintain viability. Note that mycelium cultures require basic lab skills. Handle using sterile technique to prevent contamination.
For complete descriptions of available pioppino strains, click on the names below.
NSAA1 - 'Willow Pioppino' Cyclocybe aegerita
- A commercial Pioppino culture that produces flushes of velvety-capped mushrooms with snappy stalks. These mushrooms are relatively sturdy and are not too brittle for distance shipping or delivery.
NSAA2 - Cyclocybe aegerita
- We keep multiple commercial strains on hand for customers interested in specific strains. All of our Pioppino strains will do well in the 50-65 degree range, but we've found the most consistent yields and reliable flushes with our 'Willow Pioppino' strain.
NSAA3 - Cyclocybe aegerita
- A commercial strain from fellow Maine producers, Cap N Stem.
NSAA4 - Cyclocybe aegerita
- Pioppino strain cultured from a commercial fresh mushroom distributor.
NSAA5 - Cyclocybe aegerita
- Commercial strain from WA with similar fruiting conditions as our other Pioppino strains (50-60 degrees F).
NSAC1 - Cyclocybe cylindracea
- Also known as Poplar mushrooms, these have been cultivated in Europe since Roman times and used dried and fresh in Asian cuisine. This strain originally came from Amy Fox of Fox Farm and Forage.
NSAA1 - Willow Pioppino
Cyclocybe aegerita. A commercial Pioppino culture that produces flushes of velvety-capped mushrooms with snappy stalks. These mushrooms are relatively sturdy and are not too brittle for distance shipping or delivery.
NSAA3 - Cap 'n Stem Pioppino
Cyclocybe aegerita. A commercial strain from fellow Maine producers, Cap N Stem.
NSAA5 - WA Pioppino
Cyclocybe aegerita. A commercial strain from WA with similar fruiting conditions as our other pioppino strains (50-60 degrees F).
NSAC1 - Fox Poplar
Cyclocybe cylindracea. Also known as poplar mushrooms, these have been cultivated in Europe since Roman times and used dried and fresh in Asian cuisine. This strain originally came from Fox Farm & Forage.
Frequently Asked Questions